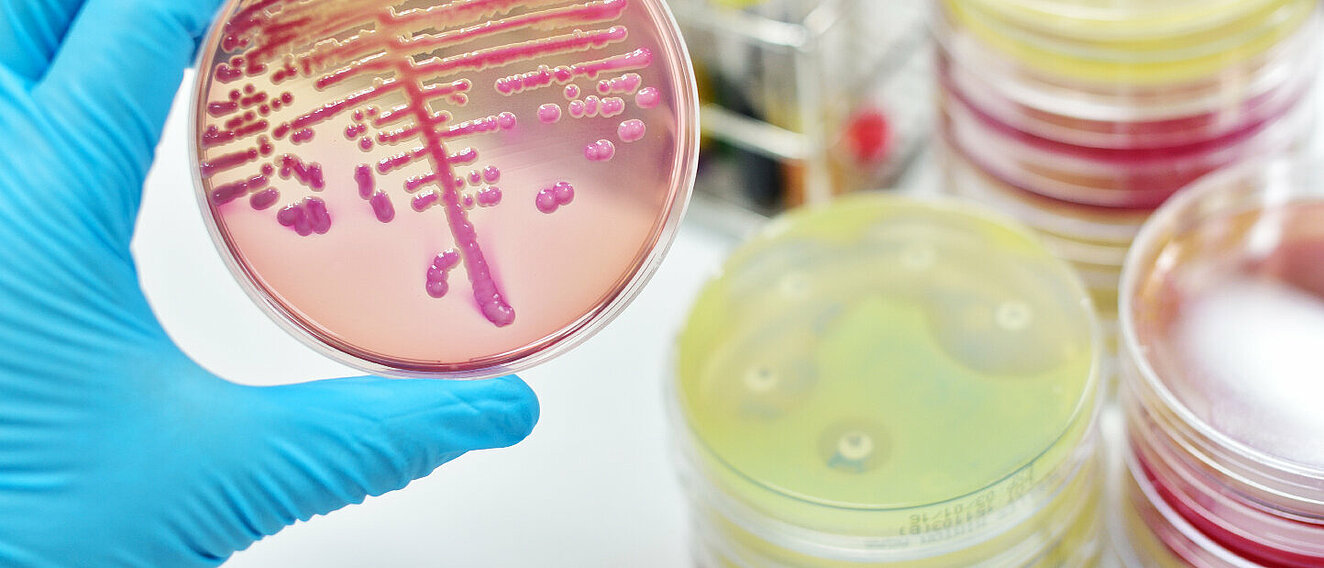

Repetitorium
BAKTERIELLE INFEKTIONEN – TEIL 1
Seite 1/1 8 Minuten
Antibiotika gehören zu den am häufigsten verschriebenen Arzneimitteln im ambulanten Bereich. In der Apotheke ist man mit der Abgabe und Beratung täglich konfrontiert, gerade Kinder und Jugendliche beziehungsweise ihre Eltern werden oft mit einem entsprechenden Rezept vorstellig. Laut Statistik erhält bundesweit jedes zweite Kind zwischen drei und sechs Jahren mindestens ein Antibiotikum pro Jahr, während es bei den Erwachsenen ungefähr jeder Dritte ist.
Ob jede dieser Verschreibungen gerechtfertigt ist, sei dahingestellt, die Debatte über unnötige Antibiotika-Verordnungen ist jedoch weiterhin aktuell. Liegt eine bakterielle Infektion vor, ist es jedoch wichtig, diese zu bekämpfen. Je nach Erreger können ansonsten im schlimmsten Fall lebensbedrohliche Zustände die Folge sein. Daher kommt der korrekten Anwendung und Dosierung der verordneten antibiotischen Wirkstoffe eine wichtige Bedeutung zu. Dieser Repetitoriumsteil beschäftigt sich nun zum einen mit den Grundlagen bakterieller Infektionen und indizierter Antibiose. Zum anderen wird das Thema bakterielle Infektionen der oberen und unteren Atemwege behandelt.
Der Feind ist überall Klingt zunächst übertrieben, entspricht aber der Realität: Wir können uns theoretisch überall und zu jeder Zeit mit Bakterien infizieren. Die Infektionswege reichen von verunreinigten Nahrungsmitteln über den Austausch von Körperflüssigkeiten bis hin zu Tröpfchen- und Schmierinfektionen. Bei intakten Barrieren (Haut, Schleimhäute) findet das Eindringen aktiv statt, die Mikroben haften sich mittels so genannter Adhäsine an Rezeptoren ihrer jeweiligen Zielstrukturen an und gelangen so in den Körper. Bei geschädigten Barrieren (zum Beispiel einer Wunde) läuft dieser Vorgang passiv ab.
Sind die Erreger einmal in den Körper gelangt, muss es nicht zwangsläufig zu einer Vermehrung und Infektion kommen, dies ist abhängig von der Konstitution des Organismus und dem beteiligten Erreger. So ist auch nicht jede bakterielle Infektion direkt behandlungsbedürftig, ein Beispiel hierfür wäre die akute Mittelohrentzündung, die vor allem Kleinkinder und Kinder betrifft. Kinderärzte empfehlen mittlerweile bei unkomplizierten Verläufen eher schmerzstillende Medikamente und Nasentropfen. Von der Inkubationszeit spricht man dann als dem Zeitraum zwischen dem Eindringen des Erregers und dem Auftreten erster Symptome. Auch das ist unterschiedlich, das können bei Diphterie zwei bis fünf Tage sein, bei Lepra sogar bis zu 20 Jahre.
Bakterien nutzen auch gerne ein geschwächtes Immunsystem aus, um sich breit zu machen. Kommt beispielsweise zu einer viralen Erkrankung, mit der das Immunsystem schon ordentlich zu tun hat, noch eine bakterielle Infektion dazu, spricht man von einer Superinfektion. Zudem lassen sich die Bakterien noch in obligat pathogen und fakultativ pathogen unterscheiden. Letztere, wie zum Beispiel Enterokokken oder Enterobakterien, werden für den Organismus nur bedrohlich, wenn sie auf ein geschwächtes Immunsystem treffen, zum Teil sind sie sogar Bestandteil der Normalflora. Oder sie gelangen in ein Körpersegment, in das sie nicht gehören, wie es auch beim Harnwegsinfekt der Fall ist.
Hier gelangen normalerweise im Darm heimische E. coli-Bakterien in die Blase und lösen dort eine Entzündung aus. Obligat pathogen nennt man einen Erreger dann, wenn eine Infektion immer auch Krankheitswert hat, dazu gehören beispielsweise Legionellen oder Mykobakterien. Eine bakterielle Infektion weist oftmals keine spezifischen Symptome auf, Fieber, Abgeschlagenheit, Blässe, eventuell gerötete Haut oder Magen-Darm-Beschwerden können ebenso bei viralen oder Pilzinfektionen auftreten. Bei diffuser Symptomatik kommen dann oftmals labordiagnostische Mittel zum Einsatz. Mit Hilfe einer Blutuntersuchung können Entzündungsmarker im Blut (C-reaktives Protein, Blutsenkungsgeschwindigkeit, Leukozyten) identifiziert werden, sie geben einen ersten Hinweis auf eine Infektion.
Die genaue Erregerbestimmung lässt sich mit einer kleinen Menge Sekret, einem Abstrich oder einer Blutprobe durchführen. Im Anschluss kann dann ein spezifisches Antibiotikum verordnet werden. Sollte dies nicht anschlagen, kann mit dem identifizierten Erreger der Probe ein Antibiogramm erstellt werden. Bei diesem Agar- oder Plattendiffusionstest wird die Probe dünn auf einen Agar-Nährboden aufgetragen und mit kleinen Plättchen, die verschiedene Antibiotika enthalten, belegt. Die Wirkstoffe diffundieren in das Medium und hemmen, im besten Fall, das Bakterium in seinem Wachstum. Das Ausmaß der Wirksamkeit lässt sich dann an der Größe der sogenannten Hemmhöfe um die jeweiligen Plättchen bestimmen. In manchen Fällen lässt sich sogar vorbeugen: Gegen bestimmte Bakterien existieren mittlerweile Impfstoffe, wie zum Beispiel gegen Meningokokken, Pneumokokken, Cholera, Diphtherie, Keuchhusten oder Typhus.
Der Winter naht, Atemwegserkrankungen auch Wer die Winterbevorratung plant, weiß, was in der nasskalten Jahreszeit an Lager sein muss: Roxithromycin, Azithromycin, Penicilin und Amoxicillin – je nach Verschreibungs-Vorliebe der umliegenden Arztpraxen. Zur Winterzeit häufen sich die Atemwegserkrankungen, dabei sind sowohl die oberen (Sinusitis, Rhinitis, Rachen- und Mandelentzündung) als auch die unteren Atemwege (akute Bronchitis, Pneumonie) betroffen. Nun werden diese Krankheitsbilder zwar vorrangig durch „respiratorische Viren“ ausgelöst, ist die Schleimhaut aber einmal geschädigt, können bakterielle Superinfektionen die Folge sein.
Zudem sind durch eine chronisch entzündliche Atemwegserkrankung (Asthma, COPD, Mukoviszidose) vorgeschädigte Personen besonders durch eine bakterielle Infektion gefährdet. Exazerbationen, also akute Verschlechterungen ihres Krankheitsbildes, und eine deutliche Einbuße der Lungenfunktion können eintreten. Oftmals kann nach Abklingen der Exazerbation nicht mehr der vorherige Gesundheitsstatus erreicht werden. Bei den bakteriellen Infektionen spielen neben ambulant erworbenen Atemwegserkrankungen zum Beispiel mit dem Problemkeim Pseudomonas aeruginosa, hier die klassischen Erreger der Lungenentzündung nach wie vor die Hauptrolle.
Streptococcus pneumoniae gehört dabei zu den Hauptübeltätern. Bei einer Pneumonie entzündet sich das Lungengewebe, je nach Art der Entzündung sind die Lungenbläschen oder auch das Gewebe zwischen den Lungenbläschen und den Blutgefäßen betroffen. Dadurch werden die für den Gasaustausch benötigten Hohlräume durch Eiter und Wassereinlagerungen verdichtet, als Folge können sich akute Lungenschädigungen oder akutes Lungenversagen entwickeln. Dabei treten schwere Symptome wie Luftnot oder Sauerstoffmangel oft ohne Vorwarnung auf, die Sterblichkeitsrate liegt auch hierzulande bei über zehn Prozent.
Meist wird daher schnell ein Antibiotikum verordnet, auch wenn der genaue Erreger noch nicht bekannt ist. Mittel der ersten Wahl sind beta-Lactam-Antibiotika wie Penicillin V oder das mittlerweile bevorzugt eingesetzte Amoxicillin. Wird der genaue Erreger während der Behandlung identifiziert, kann die Antibiose noch umgestellt oder ergänzt werden. In manchen Fällen können nämlich auch atypische Erreger, wie Chlamydien, Mykoplasmen oder Legionellen, für eine Pneumonie verantwortlich sein. Dann kämen Makrolide wie Azithromycin oder je nach Krankheitsverlauf auch Kombinationen verschiedener Antibiotika-Gruppen (Cephalosporine, Fluorchinolone) zum Einsatz.
In der Apotheke begegnet man in der Regel allerdings eher unkomplizierten respiratorischen Infektionen. Ein Großteil der Erkrankungen ist viral bedingt, durchschnittlich leiden nur zehn Prozent an einer bakteriellen Infektion. Dabei können vor allem Streptokokken, Staphylokokken, Pneumokokken oder auch Hämophilus influenzae (H. influenzae) nachgewiesen werden. Letztgenannter Keim tritt auch gerne in Form einer Superinfektion nach einer Grippe oder Erkältung auf.
Ein paar Lungenspezialisten Neben den klassischen Erkältungskrankheiten existieren noch weitere vor allem die unteren Atemwege betreffende bakterielle Infektionen. Einige sind in Deutschland aufgrund der Impfsituation und Hygienebedingungen nicht mehr häufig anzutreffen, andere gelten als Kinderkrankheiten, können aber ebenso einen erwachsenen Menschen betreffen. Ein prominentes Beispiel hierfür ist Keuchhusten. Die durch Bordetella pertussis ausgelöste hochansteckende Infektionskrankheit betrifft vor allem Jugendliche und Erwachsene ohne ausreichenden Impfschutz und nicht nur Kleinkinder und Säuglinge, wie viele denken.
Typischerweise treten drei Stadien im Krankheitsverlauf auf: Nach anfänglichen grippeähnlichen Symptomen wie Fieber und trockenem Reizhusten schließt sich das zweite Stadium mit plötzlich einsetzenden Hustenattacken an, während denen häufig glasiger Schleim hochgewürgt oder erbrochen wird. Anschließend nimmt die Anzahl der Hustenattacken langsam ab und sie fallen auch nicht mehr so stark aus. Insgesamt können bis zur Ausheilung mehrere Wochen vergehen, weshalb Keuchhusten auch als 100-Tage-Husten bezeichnet wird. Mit einer 15- bis 20-prozentigen Wahrscheinlichkeit treten Pneumonien als Komplikationen auf, auch Mittelohrentzündungen können die Infektion begleiten. Gegen die gramnegativen Stäbchen werden in der Regel Makrolide wie Erythromycin, Clarithromycin oder Azithromycin eingesetzt, bei Resistenzen auch Cotrimoxazol. Ein Einsatz empfiehlt sich vor allem innerhalb der ersten Phase, also der ersten ein bis zwei Wochen, wenn der Betroffene noch den Erreger ausscheidet.
Ein weiteres Beispiel für eine primär Kinder betreffende bakterielle Infektion, die durch A-Streptokokken, vor allem Streptokokkus pyrogenes, ausgelöst wird, ist Scharlach. Die Krankheit beginnt meist sehr plötzlich, es kommt zu hohem Fieber, Schluckbeschwerden und Halsschmerzen, oft einhergehend mit Schüttelfrost und Übelkeit. Später erscheinen am ganzen Körper rote, etwa stecknadelkopfgroße Flecken, wobei ein Dreieck zwischen Mund und Kinn ausgespart wird (periorale Blässe). Ein typisches Symptom ist zudem die sogenannte Himbeerzunge, die gerötet und hubbelig erscheint. Zum Einsatz kommt vorwiegend Penicillin V.
Die Therapie sollte konsequent zehn Tage lang durchgeführt werden, da so das Risiko für Komplikationen wie Streptokokken-Nephritis, rheumatisches Fieber oder Entzündungen der Herzinnenhaut reduziert werden kann. Bei einer Unverträglichkeit kann auf Makrolide wie Erythromycin oder Clarithromycin ausgewichen werden. Die lebensbedrohliche Diphtherie kommt in Deutschland aufgrund der Impfempfehlung zum Glück nur noch selten vor. Übeltäter ist das Toxin des grampositiven Corynebacterium diphtheriae, es löst die mitunter sehr schweren Krankheitsverläufe aus. Diphtherie kann sowohl die Schleimhäute der Atemwege (Rachen-, Kehlkopf-, Nasendiphtherie) als auch die Haut (Wunddiphtherie) betreffen.
Sie beginnt noch ganz unscheinbar: allmählich einsetzendes Krankheitsgefühl mit Halsschmerzen, leichtem Fieber, Schluckbeschwerden, Heiserkeit und Lymphknotenschwellungen. Dann entstehen aber die typischen Pseudomembranen, lederartige braune Beläge auf Kehlkopf und Luftröhre aus abgestorbener Schleimhaut und Blutbestandteilen, woher die Krankheit ihren volkstümlichen Namen Halsbräune hat. Ebenfalls charakteristisch ist ein süßlicher Mundgeruch. Schwillt der Hals im Krankheitsverlauf stark zu, kann es als schwerwiegende Komplikation zum Ersticken kommen. Weitere lebensbedrohliche Komplikationen sind Herzmuskel-, Nerven- oder Nierenentzündungen, die entstehen können, wenn das Toxin über die Blutbahn zu anderen Organen gelangt. Neben Penicillin V für konsequente zehn Tage wird ein Antikörper-Serum verabreicht, das das Diphtherie-Toxin bindet und somit unschädlich macht.
Tuberkulose gehört weltweit zu den zehn häufigsten Todesursachen – mit zunehmender Häufigkeit. In Deutschland ist vor allem Mycobacterium tuberculosis für eine Infektion verantwortlich, es kommen aber auch Erregernachweise von Mycobacterium bovis, Mycobacterium africanum oder Mycobacterium microti vor. Die auch als Schwindsucht, Motten oder weiße Pest bezeichnete Infektionskrankheit betrifft vor allem die Lungen. Zur Behandlung stehen verschiedene Antibiotika zu Verfügung. Da diese speziell gegen Mykobakterien wirksam sind, werden sie auch Antituberkulotika genannt. Die Gefahr von Rezidiven und eine verschärfte Resistenzlage bedingen eine nach Vorgabe der Weltgesundheitsorganisation vorgeschriebene Einnahme von mindestens einem halben Jahr.
Untypische Symptome, vor allem in der ersten Zeit, sind Müdigkeit, Schwäche, Appetitlosigkeit, Fieber und geschwollene Lymphknoten. Schwere Verläufe sind geprägt von typischen Hustenattacken mit Luftnot und blutigem Auswurf, desweiteren Blutarmut und Untergewicht. Organschäden sind keine Seltenheit, im schlimmsten Fall kann eine Tuberkulose auch tödlich verlaufen. Die Therapie setzt sich aus zwei Phasen zusammen: Die ersten zwei Monate kommt eine Kombination aus Isoniazid, Rifampicin, Pyrazinamid und Ethambutol oder Streptomycin zum Einsatz. Anschließend muss der Betroffene in einer Stabilisierungsphase von vier Monaten die Therapie mit Isoniazid und Rifampicin fortsetzen. Auch wenn dann schon längst keine Beschwerden mehr vorliegen, ist es sehr wichtig, die Therapie nicht vorzeitig abzubrechen.
Den Artikel finden Sie auch in die PTA IN DER APOTHEKE 10/18 ab Seite 86.
Farina Haase, Apothekerin/Redaktion